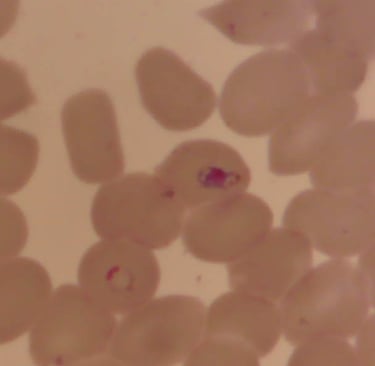
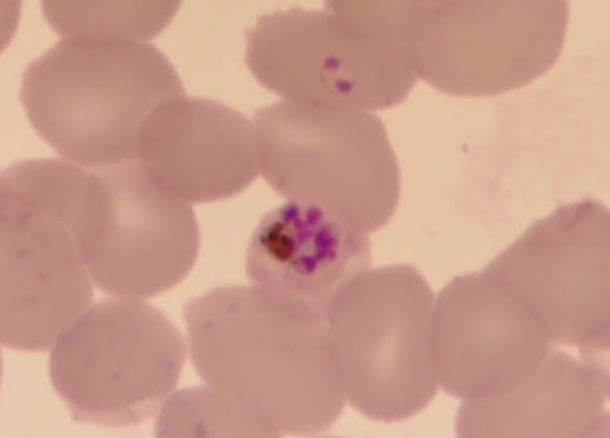
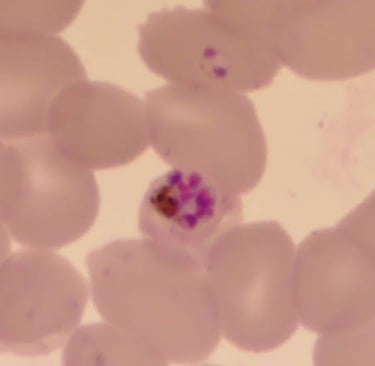

Guia Parasitológico - Protozoários
Entamoeba dispar/histolytica
Formas evolutivas:
Trofozoíto: mede 20 até 40µm; geralmente em um só núcleo, bem nítido nas formas coradas e pouco visíveis nas formas vivas; apresenta-se pleomórfico, ativo, alongado, com emissão continua e rápida de pseudópodes, grossos e hialinos; movimento direcional; citoplasma apresenta-se em ectoplasma (claro e hialino) e endoplasma (finamente granuloso com vacúolos, núcleo e resto de substâncias alimentares); membrana nuclear delgada e a cromatina justaposta a ela; no centro do núcleo encontra-se o cariossoma (endossomo).
Cisto: esféricos ou ovais, medindo 8 a 20µm de diâmetro; núcleos variam de 1 a 4 com membrana nuclear escura devido ao revestimento da cromatina; cariossoma pequeno situado no centro do núcleo; corpos cromatoides (quando presentes) tem forma de bastonetes com pontas arredondadas.
Doença associada: Amebíase


Trofozoíto de Entamoeba dispar/histolytica
Imagem capturada com a objetiva no aumento de 100x
Fonte: Acervo da Disciplina de Parasitologia (DMIP/FCM/UERJ


Cisto de Entamoeba dispar/histolytica
Imagem capturada com a objetiva no aumento de 100x
Fonte: Acervo da Disciplina de Parasitologia (DMIP/FCM/UERJ)
Giardia sp.
Formas evolutivas:
Trofozoíto: formato de pera (piriforme), simetria bilateral; mede 20µm de comprimento por 10µm de largura; apresenta quadro pares de flagelos (um par anterior, um par ventral, um par posterior e um par caudal); a face dorsal é lisa e convexa e a fase ventral é côncava; apresenta uma estrutura semelhante a uma ventosa (disco ventral, adesivo ou suctorial)
Cisto: forma oval ou elipsoide; mede aproximadamente 12µm de comprimento por 8µm de largura; apresenta uma parede externa glicoproteica com espessura que varia de 0,3 a 0,5µm.
Doença associada: Giardíase


Trofozoíto de Giardia sp.
Imagem capturada com a objetiva no aumento de 100x
Fonte: Acervo da Disciplina de Parasitologia (DMIP/FCM/UERJ)


Cisto de Giardia sp.
Imagem capturada com a objetiva no aumento de 100x
Fonte: Acervo da Disciplina de Parasitologia (DMIP/FCM/UERJ)
Leishmania sp.
Formas evolutivas:
Promastigota: forma alongada, medindo 10-40 x 1,5-3µm; flagelo livre e longo emergindo do corpo do parasito na sua porção anterior; núcleo arredondado ou oval, situado na região mediana ou ligeiramente na porção anterior do corpo; cinetoplasto na forma de bastão, localiza-se na porção mediana entre a extremidade anterior e o núcleo.
Amastigota: esféricos ou ovais, medindo 1,5-3 x 3-6,5µm; núcleo grande e arredondado, ocupando às vezes um terço do porto do parasito; cinetoplasto em forma de bastonete; membrana celular apresenta uma invaginação na região anterior do corpo do parasito formando a bolsa flagelar, onde se localiza o flagelo; o flagelo não se exterioriza para além do corpo do parasito.
Doença associada: Leishmaniose


Forma Promastigota de Leishmania sp
Imagem capturada com a objetiva no aumento de 100x
Fonte: Acervo da Disciplina de Parasitologia (DMIP/FCM/UERJ)


Macrófago infectado com amastigotas de Leishmania sp Imagem capturada com a objetiva no aumento de 100x
Fonte: Acervo da Disciplina de Parasitologia (DMIP/FCM/UERJ)
Plasmodium sp.
Formas evolutivas:
Esporozoíto: alongado, medindo 11x1µm; núcleo central; membrana formada por duas camadas.
Merozoíto: semelhante ao esporozoíto, medindo 1-5x2µm; membrana externa composta por 3 camadas.
Trofozoíto jovem: ameis de corpo delgado e delicado com cromatina saliente.
Microgameta: célula flagelada, medindo 20-25µm; constituída por uma membrana que envolve o núcleo e o único flagelo.
Macrogameta: apresenta uma estrutura proeminente na superfície, por onde ocorre a penetração do microgameta.
Oocineto: forma alongada, medindo 10-20µm; núcleo volumoso e excêntrico.
Oocisto: estrutura esférica de 40-80µm; apresenta grânulos pigmentados; envolto por uma capsula com espessura em torno de 0,1µm.
Doença associada: Malária

Gametócito de Plasmodium sp.
Imagem capturada com a objetiva no aumento de 100x
Fontes: Acervo da Disciplina de Parasitologia (DMIP/FCM/UERJ)


Trofozoíto jovem de Plasmodium sp.
Imagem capturada com a objetiva no aumento de 100x
Fonte: Acervo da Disciplina de Parasitologia (DMIP/FCM/UERJ)

Esquizonte de Plasmodium sp.
Imagem capturada com a objetiva no aumento de 100x
Fonte: Acervo da Disciplina de Parasitologia (DMIP/FCM/UERJ)
Trypanosoma cruzi
Formas evolutivas:
Epimastigota: forma alongada com cinetoplasto justa-nuclear e anterior ao núcleo; possui pequena membrana ondulante lateralmente disposta
Tripomastigota: forma infectante, corpo fusiforme com cinetoplasto em posição terminal posterior ao núcleo; o flagelo forma uma extensa membrana ondulante e torna-se livre na porção anterior da célula; encontrado no sangue periférico do hospedeiro vertebrado e nas porções terminais do tubo digestivo e de Malpighi do inseto vetor.
Amastigota: forma arredondada ou oval, com flagelo curto não exteriorizado, medindo entre 2 e 4µm de diâmetro, responsáveis pela multiplicação binária do parasito no hospedeiro vertebrado.
Doença associada: Doença de Chagas


Trypanosoma cruzi – Forma Epimastigota
Imagem capturada com a objetiva no aumento de 100x
Fonte: Acervo da Disciplina de Parasitologia (DMIP/FCM/UERJ)


Trypanosoma cruzi – Forma Tripomastigota
Imagem capturada com a objetiva no aumento de 100x
Fonte: Acervo da Disciplina de Parasitologia (DMIP/FCM/UERJ)


Trypanosoma cruzi – Ninho de amastigota em tecido cardíaco murino
Imagem capturada com a objetiva no aumento de 100x
Fonte: Acervo da Disciplina de Parasitologia (DMIP/FCM/UERJ)
Fontes:
Coura, José Rodrigues. Dinâmica das doenças infecciosas e parasitárias. 12 ed. Rio de Janeiro, Guanabara Koogan, 2013
Neves,David Pereira. Parasitologia Humana. 12 ed, São Paulo, Editora Atheneu, 2011



